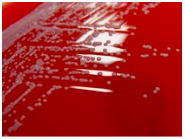
Blood Agar Test Results

First Identification Test: Gram Stain
Based on the Gram stain image provided in the lab manual, the cells observed are rod-shaped and have a pink/red coloration, indicating that they did not retain the crystal violet stain and are, therefore, Gram-negative. The cells appear to have a uniform shape and size, with no visible irregularities or structures. Gram-negative cells have a thinner peptidoglycan layer in their cell wall. Hence, it does not hold the crystal violet-iodine complex during the Gram staining procedure and thus appears pink/red after the counterstain with safranin (Watson, n.d.). This result suggests that the unknown organism in this lab report is a Gram-negative rod.

Second Identification Test: Catalase Test
Description
The second identification test, the catalase test, was chosen because it aids in distinguishing between bacteria that produce the catalase enzyme and those that do not. This test is crucial because it can help to identify the possible bacterial species that may be present and help to reduce their number.
Steps of the Catalase Test
- Make a fresh bacterial culture by placing a loopful on a spotless microscope slide.
- Add a hydrogen peroxide (H2O2) solution to the bacterial culture on the slide. Add a drop of 3% hydrogen peroxide solution.
- Check for bubble production: Check if bubbles appear immediately on the slide. Bubbles show that the catalase enzyme, which catalyzes the conversion of hydrogen peroxide to water and oxygen gas, is active.
- Interpret the findings: the presence of bubbles after the test signifies catalase-positive bacteria, while the absence of bubbles indicates catalase-negative bacteria.
Observed Results
The observed results of the Catalase Test were positive. There was immediate bubbling after adding hydrogen peroxide to the bacterial colony, showing that the catalase enzyme was present. Bubbling results when catalase breaks down hydrogen peroxide into water and oxygen gas. A positive result for the Catalase Test indicates that the unknown organism produces the enzyme catalase.

Interpreting Catalase Test Results
The Catalase Test results show that the unidentified organism is producing catalase. The capacity to synthesize the enzyme catalase, which converts hydrogen peroxide into water and oxygen, indicates that the organism can do so. Because not all bacterial species can produce catalase, this information can help narrow down the potential identification of the organism.
A member of the family Enterobacteriaceae, comprising several common Gram-negative bacteria like Escherichia coli and Salmonella, the unidentified organism is most likely a member, according to the positive catalase test in particular. Known to produce catalase, these microorganisms are frequently linked to human and animal infections (Watson, n.d.). As a result, the findings from the catalase and Gram stain tests indicate that the unidentified organism in this lab report is likely an Enterobacteriaceae-related Gram-negative rod.
Third Identification Test: Blood Agar Growth and Hemolysis Test
Description
The Blood Agar Growth and Hemolysis test was chosen to determine whether the unidentified organism can grow on blood agar and to pinpoint the kind of hemolysis the organism produces. Based on the type of hemolysis produced by the bacteria, which can be alpha, beta, or gamma hemolysis, this test can assist in differentiating between various bacterial species. This test can yield valuable data for further characterization because our unidentified organism may be pathogenic and has not yet been identified.
Steps of the Blood Agar Test
- Obtain a sterile blood agar plate.
- Inoculate the plate with the unknown organism using a sterile loop or swab.
- Incubate the plate at the appropriate temperature and atmospheric conditions for the unknown organism.
- Examine the plate for signs of growth and hemolysis.
Observed Results
The test results were negative for hemolysis, which means that the blood agar plate around the bacterial colonies did not change color. This observation suggests that the unidentified organism cannot lyse red blood cells because it does not produce hemolysins.
Interpreting Test Results
The Blood Agar Growth and Hemolysis test showed that the unidentified organism is non-hemolytic, which limits the possible identification of the organism to those that do not produce hemolysins (Watson, n.d.). Hemolysis is an essential trait associated with an organism’s virulence and pathogenicity; the absence of hemolysis in this test indicates that the unknown organism lacks this ability.
Identified Organism
Escherichia coli.
Kirby-Bauer Diffusion Test
Description
The disk diffusion test, also called the Kirby-Bauer diffusion test, is a laboratory procedure used to assess the potency of antibiotics against particular bacterial strains. In this test, filter paper disks with various antibiotics are placed on top of a petri dish covered with a standard culture of bacteria. When the antibiotics diffuse from the disks into the surrounding agar, they create a concentration gradient. If the antibiotic successfully stops the bacterial strain’s growth, a distinct zone of inhibition will appear around the disk (Watson, n.d.). The zone of inhibition is measured and compared to the approved criteria to establish if the bacterial strain is susceptible, resistant, or intermediate to the antibiotic.
Test Results and Antibiotic Susceptibility
The observed zone of inhibition measurements show that the unknown organism, E. Coli, is susceptible to doxycycline and immediately susceptible to ciprofloxacin and amoxicillin.

Antibiotic Selection
Doxycycline is the most effective antibiotic for treating the organism mentioned in part E. The organism appears to be very susceptible to this antibiotic because it has the largest zone of inhibition (Watson, n.d.). Since both ciprofloxacin and amoxicillin fall into the intermediate range, they may still be clinically effective but necessitate higher doses or longer treatment times.
Reference
Watson, R. (n.d.). Summary of biochemical tests. Microbiology Lab : MOLB 2210. Web.